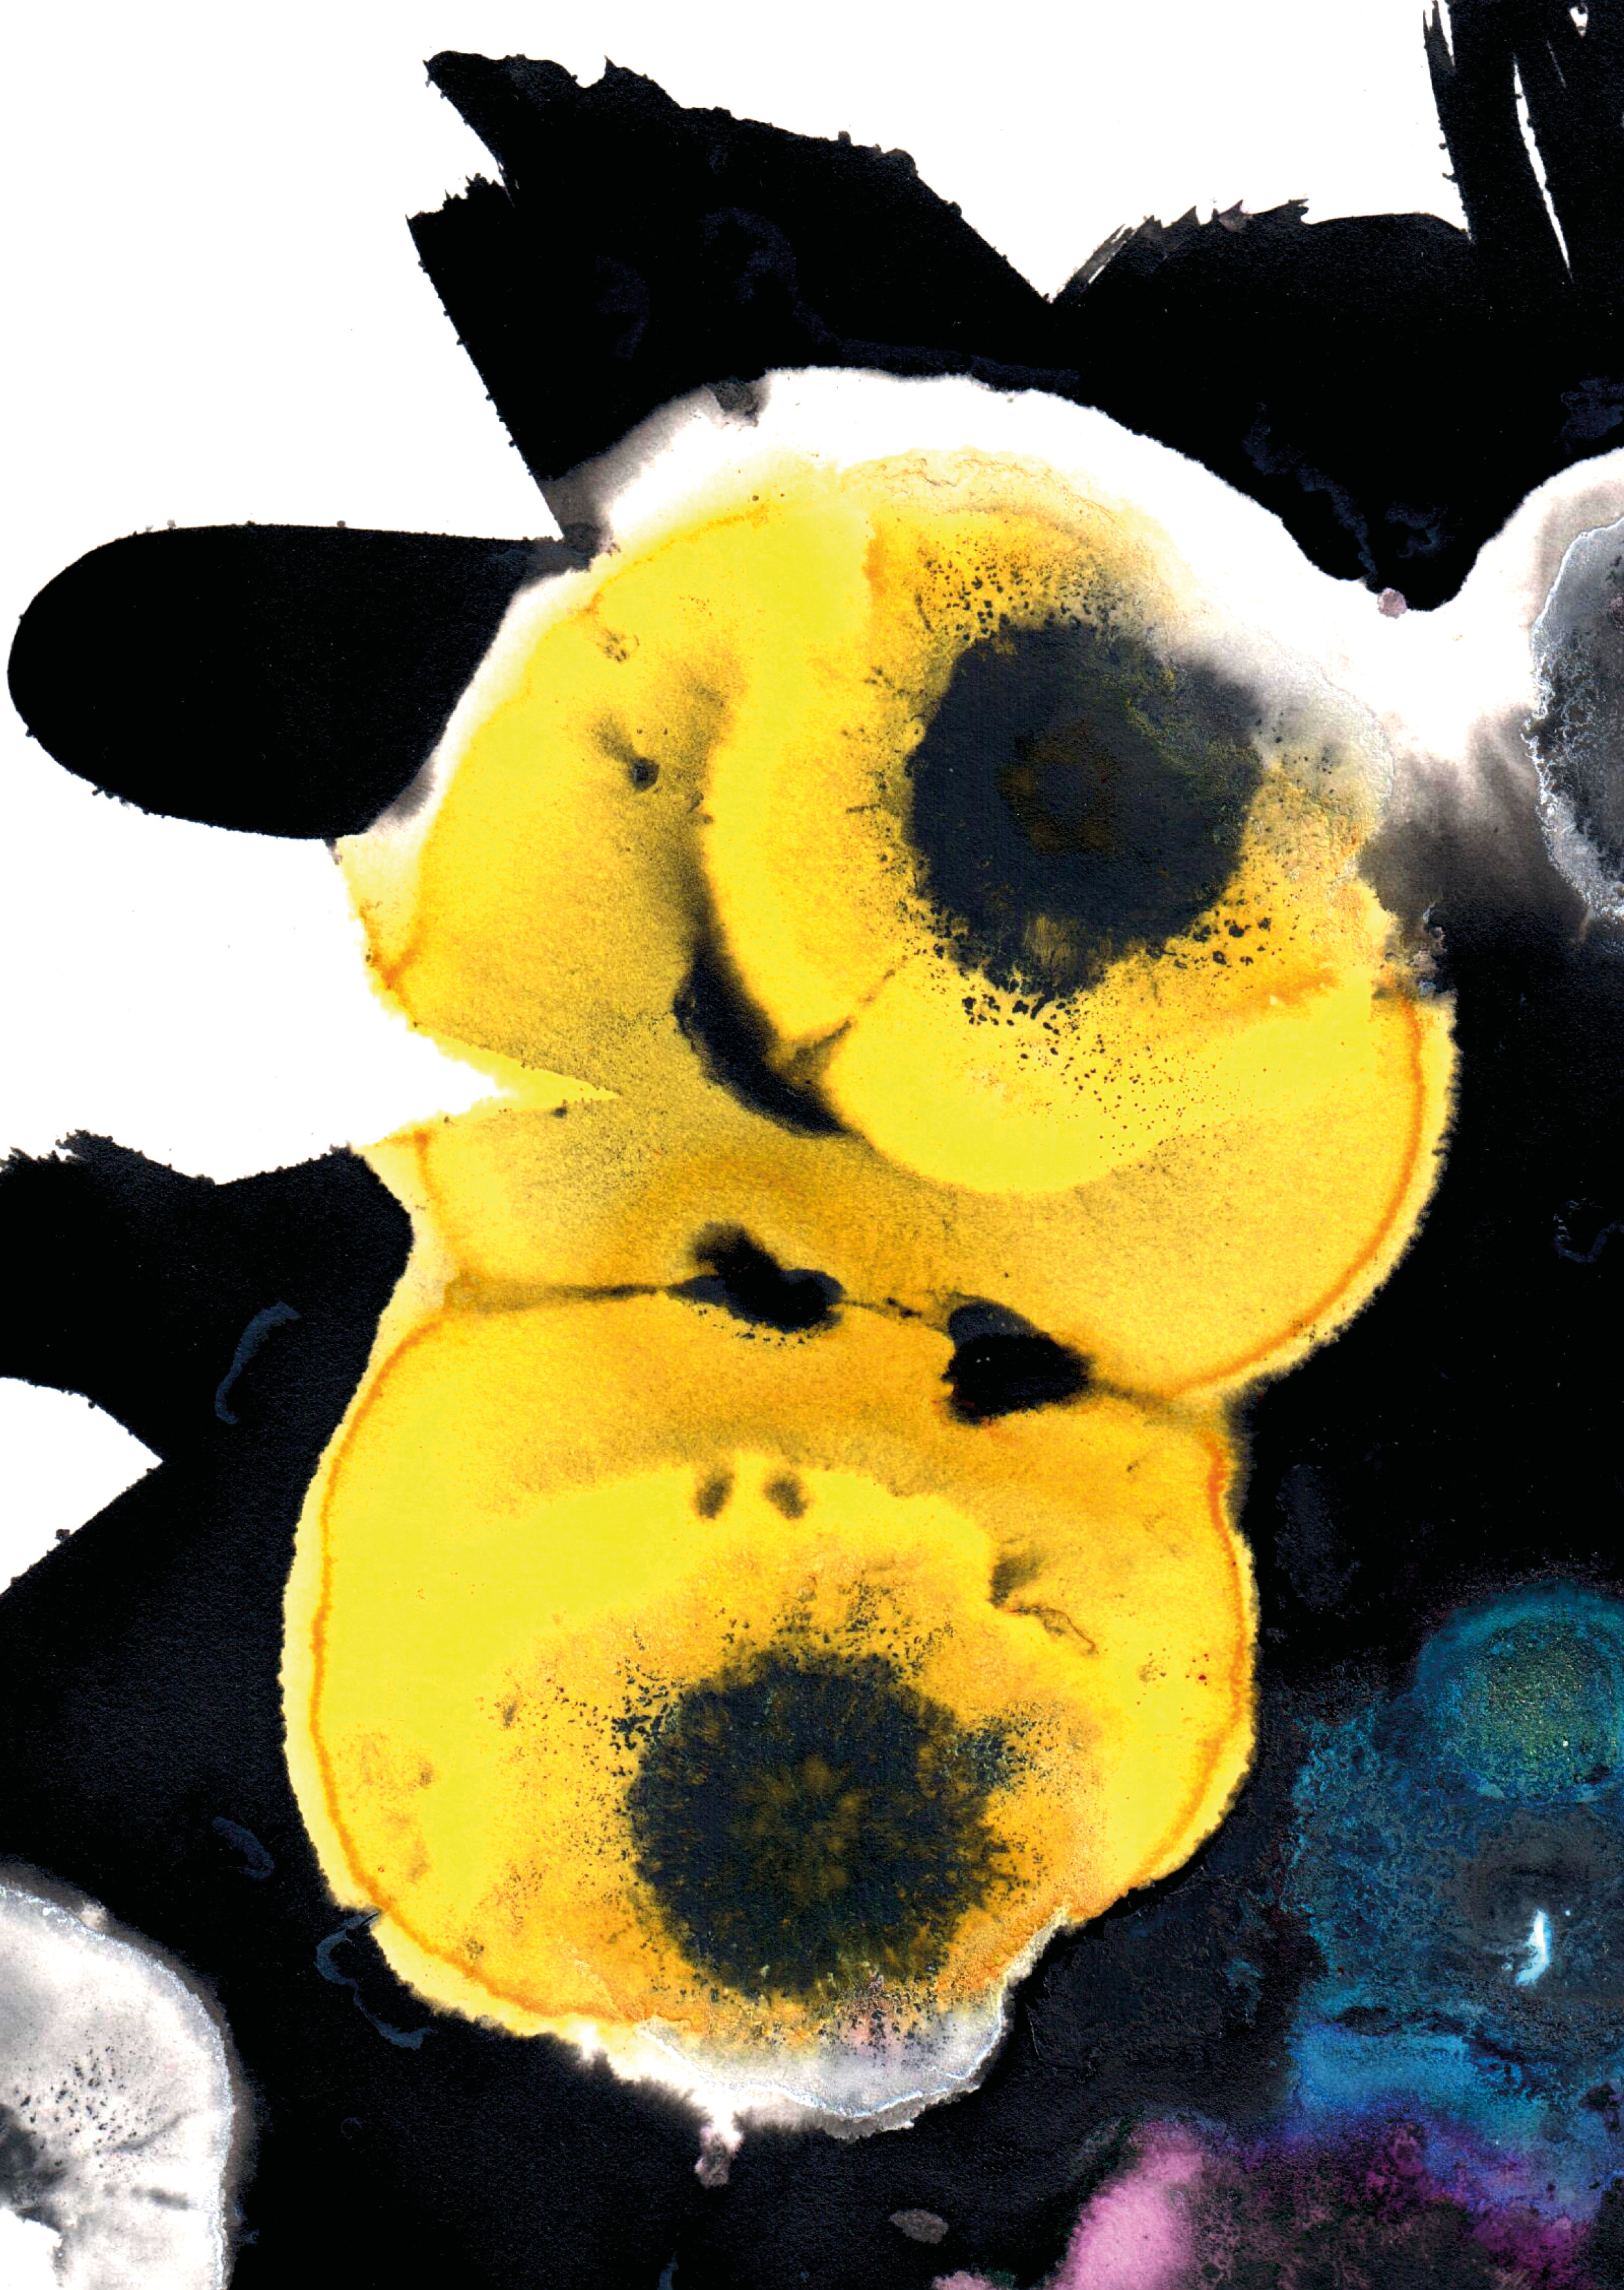

Postkarten
![]()
![]()
![]()
![]()
![]()
![]()
![]()
![]()
![]()
![]()
![]()
![]()
![]()
![]()
![]()
![]()
![]()
![]()
![]()
![]()
![]()
![]()
![]()
![]()
![]()
![]()
![]()
![]()
![]()
![]()
![]()
![]()
Abwaschprotokolle 2021
![]()
![]()
![]()
![]()
![]()
![]()
![]()
![]()
![]()
![]()
![]()
![]()
![]()
![]()
![]()
![]()
![]()
![]()
![]()
![]()
![]()
![]()
![]()
![]()
![]()
Turmbau: Benno Fosco
Foto: Jacqueline Fosco
Layout: Franca Fosco
![]()
![]()
![]()
![]()
![]() Postkartenset Stromboli Basel
Postkartenset Stromboli Basel

Abwaschprotokolle 2021

























Turmbau: Benno Fosco
Foto: Jacqueline Fosco
Layout: Franca Fosco





Geburtskarten
![]()
![]()
![]()
![]()










